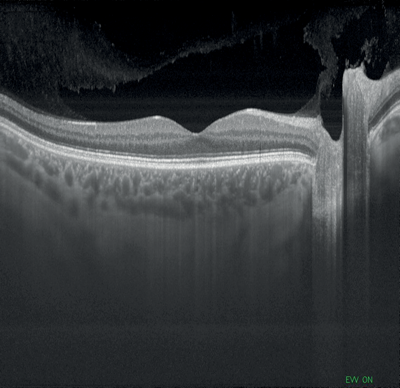

Fast-evolving technological leaps are opening the way toward clinically useful ocular coherence angiography, generating 3-dimensional microvasculature maps without intravenous dye injection, as well as whole-eye imaging, handheld patient-operated optical coherence tomography (OCT) devices and, for challenging vitreoretinal procedures, integrated intraoperative OCT devices.
Forward-looking research scientists, retina specialists and imaging device makers predict a continuing move toward non-invasive vascular imaging with sophisticated OCT technology, providing enhanced perception of microstructures and circulation, quantification of cellular-level changes and flow over time, and visualisation of microvascular structures at different depths. Multiple vendors will provide a range of ophthalmic imaging devices that include OCT angiography modules, providing greater choice for practice refinement. Patient care may be simplified through the availability and adoption of rapid multidimensional imaging technologies, argues Philip J Rosenfeld from Bascom Palmer Eye Institute in an accompanying exclusive feature.
Ultrafast image acquisition speeds pave the way for optical coherence angiography
Image acquisition speeds have increased exponentially with each new iteration of OCT technology, from 400 A-scans per second for time-domain OCT, up to 100 times faster speeds with spectral-domain OCT (SD OCT), and today 100,000 A-scans per second and higher using a frequency-swept (tunable) light source, coined swept-source OCT (SS OCT). Current commercially available SD OCT systems feature axial resolution between 4 microns and 7 microns, which is dependent on bandwidth of the light source used. Increasing the bandwidth can potentially improve axial resolution, allowing ultra-high resolution OCT and achieving axial resolution between 1 and 4 microns. Image averaging increases image quality by reducing noise.
Ultra-high resolution OCT also provides better delineation of retinal layers than conventional SD OCT, eliminating motion artifact without mechanical tracking and allowing better OCT fundus images and, importantly, 3D reconstruction with flow detection, complementing or possibly eliminating dye-based angiography. Ocular coherence angiography can produce rapid 3D maps of the retinal and choroidal vasculature, together with segmentation ability, identifying superficial and deep retinal capillaries. Clinicians can capture the motion of scattering particles such as red blood cells by viewing sequential OCT cross-sectional scans which are repeated at the same location on the retina.
In a recently-published editorial, Carmen A Puliafito (Los Angeles, USA) described OCT angiography as a true extension of capabilities from spectral-domain OCT, the latter having improved the quality of clinical decision-making, although in reality representing a refinement of the Stratus OCT approach developed by Carl Zeiss Meditec for macular diagnostics [1]. In everyday practice, added Prof Puliafito, most retinal clinicians make their decisions based on a review of the retinal topographic map and several retinal cross-sections of interest. Clinical evaluation of OCT angiography continues, while proponents and retinal specialists alike emphasise its potentially significant clinical potential. Initial published results are promising: OCT angiography can detect capillary nonperfusion as well as or better than fluorescein angiography (FA), and it’s possible to identify microvascular abnormalities associated with leakage.
Better resolution and faster speed OCT angiography may provide a better understanding of vitreoretinal disease and response to therapy with superior qualitative and quantitative data, argued Jay S Duker (Boston, USA), speaking at last year’s American Academy of Ophthalmology Retina Subspecialty Day in Chicago, USA.
A comparative evaluation of phase-variance OCT (PV-OCT) and FA in normal individuals and patients with age-related macular degeneration (AMD) and diabetic retinopathy (DR) found that phase-variance OCT, which provides volumetric imaging of the retinal vasculature, yields high-resolution imaging of the retinal and choroidal microvasculature that compares well with FA, the current gold standard for retinovascular imaging [2]. Investigators reported that the choriocapillaris was imaged with better resolution of microvascular detail using PV-OCT. Ocular coherence angiography captures retinal vascular changes using split-spectrum amplitude decorrelation angiography [SSADA) to dissect layers of vessels in the retina, and may provide relevant information on the pathophysiology of abnormalities of the retinal vasculature [3].
Multiple OCT angiography systems planned
California-based Optuvue introduced the first commercially available OCT angiography device called AngioVue, providing a non-invasive modality to image ocular microvascular function. This system integrates non-invasive ocular microvascular enhanced imaging with existing Optovue high-speed (70,000 A-scans/sec), widefield, en face spectral-domain OCT technology. AngioVue can be used to image different layers of microvasculature without the need for dye injection as a contrast medium. Conventional OCT allows visualisation of structural change, including drusen and retinal pigment epithelium (RPE) elevation. OCT angiography on the other hand identifies retinal microcirculation in ocular diseases using the intrinsic motion of blood cells in the vessel, helping visualise ocular blood flow and identify microvasculature changes such as choroidal and retinal neovascularisation.
Comparable or more advanced OCT angiography applications are in the pipeline. Heidelberg Engineering’s Spectralis OCT angiography feature is under development, to be based on the OCT2 module for the Spectralis diagnostic imaging platform. It will provide a three-dimensional reconstruction of the perfused microvasculature within the retina and choroid, allowing analysis layer-by-layer using the en-face visualisation. Depth selective OCT angiography provides structural detail of the retinal vasculature without injection, while the Spectralis OCT2 will allow simultaneous infrared cSLO and OCT angiogaphy imaging. Carl Zeiss Meditec plans to introduce OCT angiography applications suitable for both its spectral domain OCT platform and a prototype long-wavelength swept-source OCT system in development. It says it will maintain an array of clinically useful and cost-effective ocular imaging platforms and applications suited to a variety of different clinical applications, from high throughput ophthalmology clinics to smaller units requiring combined OCT and fundus imaging capabilities.
Swept-source OCT
Swept-source OCT is an important part of the future of ophthalmic imaging, argued Richard F Spaide (New York, USA), speaking during the 2014 Retina Subspecialty Day imaging session. Swept-source OCT uses a frequency-swept light source and photodetectors as well as a longer centre wavelength, the latter improving penetration through tissue and allowing simultaneous imaging of the vitreous and choroid. Sensitivity fall-off with increasing depth is less than that seen with spectral domain OCT. The main attributes of swept-source OCT are deeper range of imaging, vitreous imaging and faster scanning speed.
In contrast to a broadband super-luminescent diode, spectrometer and high-speed line-scan camera utilised for spectral domain OCT methodology, swept-source OCT uses a wavelength-sweeping laser and a dual-balanced photodetector. The wavelength tunable laser light source allows for a much higher image acquisition speed than conventional SD OCT and produces better light penetration into the deeper tissue and hence improved visualisation of the choroid, including assessment of choroidal volume.
Topcon’s newly-introduced swept-source DRI OCT Triton can capture 256 B-scans in less than three seconds, with high speed scanning of 100,000 A-scans per second and a 1050nm wavelength which can penetrate easily through cataracts and haemorrhages. It features widefield 12 by 9mm scan screens for both glaucoma and macular pathology in one scan, with consistent signal strength from cortical vitreous to the sclera with an average of up to 128 times, automatic detection of seven retinal layers, as well as 2.6 micron digital resolution. The DRI OCT Triton has a built-in high resolution colour fundus camera, fundus guided acquisition (SmarTrack) and the option of an anterior imaging module. The Triton Plus also features fundus autofluorescence and fluorescein angiography, and an OCT angiography module is currently under development.
Tomey has developed a cornea / anterior segment non-contact, non-invasive 3D imaging system based on swept-source OCT technology (OCT SS-1000 Casia). It provides high resolution imaging and 30,000 A-scans per second scanning speed and is indicated for cross-sectional imaging of the anterior segment and dimension measurements such a curvature, length, area and volume. Zeiss introduced a swept-source biometry device, providing a full-length OCT image showing anatomical details on a longitudinal cut through the entire eye, allowing detection of unusual eye geometries such as tilt or decentration of the crystalline lens (IOLMaster 700).
An observational study by Francis et al. evaluating swept-source OCT features of choroidal nevi found that SS OCT was significantly better than enhanced depth imaging-OCT, a modification of spectral domain OCT image capture, at depicting certain intralesional characteristics. Investigators noted that SS OCT penetrates melanin better and at a greater depth in the choroid compared to other OCT techniques [4]. A comparison of penetration depth in choroidal imaging from scans obtained from healthy volunteers found similar penetration depths with SS OCT and SD OCT using EDI and frame averaging, both technologies providing excellent visualisation for volumetric imaging of the choroidoscleral interface [5]. Other comparative OCT technology studies confirm that swept-source OCT shows potential for improved choroidal analysis, demonstrating enhanced visualisation of the choroidoscleral interface compared to spectral-domain OCT with and without EDI [6].
Ultra-widefield retinal imaging
Standard fundus photography requires pupillary dilation, up to 16 or more flashes per eye, and combined ETDRS seven standard fields cover less than 100 degrees of the retina, which means peripheral lesions may be overlooked. The Diabetic Retinopathy Clinical Research (DRCT.net) group’s Protocol AA prospective, observational longitudinal study is investigating peripheral DR lesions on ultra-widefield fundus images and the risk of DR worsening over time. The trial will assess whether presence or severity of peripheral DR lesions on ultra-widefield images is associated with increased rates of DR or diabetic macular oedema (DME) worsening or improvement over time.
Ultra-widefield imaging is fast evolving as a recognised standard of care for imaging the retina, especially for retinal vascular disorders. Visualisation of the retina using ultra-widefield imaging is considerably greater than that generated with traditional imaging. Ultra-widefield indocyanine green angiography has been shown to provide clinically practical detailed images of both the central and peripheral choroidal circulation in patients with a variety of retinal conditions, including central serous chorioretinopathy, and can help detect additional retinal pathology missed on standard fundus photography [7]. Ultra-widefield fluorescein angiography effectively images a number of abnormal retinal conditions, such as diabetic retinopathy, retinal vein occlusion, sickle cell retinopathy, choroiditis, uveitis and paediatric retinal disease [8].
Widefield systems such as Optos Optomap and Heidelberg Spectralis noncontact ultra-widefield module provide excellent views of the peripheral retina. The noncontact widefield module from Heidelberg allows for 110˚ views of the fundus. Optos offers Daytona, an ultra-widefield digital, non-mydriatic, ultra-widefield scanning laser ophthalmoscope that captures images through 2mm pupils and generates ultra-widefield optomap images, providing a simultaneous view of the central pole, mid periphery and periphery. Its Virtual Point technology provides a 200˚ view of the retina in one panoramic image, with additional ultra-widefield autofluorescence capabilities for assessment of deeper structures of the retina and visualisation of lipofuscin in the RPE. The capture of the 200˚ field in one image allows full diagnostic examination of retinal disease, as progression of the contrast dye across the retinal surface is caught at every stage. Although all widefield devices produce distortion or non-linearity, specially developed software from Optos provides more accurate representations of the fundus, as well as measurement and quantification of peripheral pathologies.
Future directions
Optical coherence angiography and whole-eye or binocular OCT are the two main imaging developments that are likely to change the practice of clinical ophthalmology in the near future, argued Pearse Keane (London, UK) in a presentation on future retinal imaging technologies at the 2015 Trends in Ophthalmology meeting in London [9]. Limitations of conventional SD-OCT systems include large size, expense and a requirement for trained skilled operators, together with limited depth imaging capability. While there are many exciting ocular imaging enhancements being developed, enhanced resolution or complex analyses provided by newer faster-scanning imaging systems must nonetheless result in clear demonstrable benefit for patients to warrant broad adoption, added Mr Keane.
Grulkowski and colleagues demonstrated the use of ultra-high speed swept-source OCT using vertical-cavity surface emitting laser (VCSEL) technology for retinal, anterior segment and full eye imaging; an imaging depth of ~50 mm was achievable, with in vivo 3D OCT imaging that spanned the entire eye [10]. Different device solutions are being developed for intraoperative OCT, including handheld SD OCT probe and microscope-integrated intraoperative OCT systems, with potential clinical applications for macular hole, vitreomacular traction, epiretinal membrane and retinal detachment. The development and introduction of handheld OCT devices may further allow automated self-directed virtual eye examinations, including assessment of visual acuity and pupillometry.
Multidimensional imaging is the future of ophthalmology:
an interview with Philip J Rosenfeld
“The slogan often used in ophthalmology is multimodal imaging, because in the past we have used colour fundus photography, autofluorescence imaging, different kinds of reflectance imaging, and OCT imaging so we can understand ocular diseases. The focus of many scientific meetings currently is on en face OCT imaging and the benefits of segmentation algorithms so that we can dissect the layers of the retina and choroid to better understand disease processes and follow patients in clinic as they undergo therapy. The major disease entities where these technologies are going to have an impact are diabetes, vein occlusion and AMD. In addition to imaging in three dimensions, we now have a fourth dimension to consider, and that’s OCT angiography. With OCT angiography, we are entering an age of multidimensional imaging. While there are obvious benefits for clinical research, the question I always pose is, ‘how does OCT angiography impact patient management?’ The benefits of OCT angiography in clinical care remain to be elucidated.
Figures 1-4: Swept-source OCT (DRI OCT-1 Triton, Topcon) images of healthy eyes that clearly delineate features in the vitreous, including area of Martegiani, bursa premacularis and posterior hyaloid, right through to the sclera, in the same single scan.
Figure 5: Colour fundus photograph of healthy eye taken
using swept-source OCT (DRI OCT-1 Triton, Topcon).
“One limitation of OCT angiography is that it does not show leakage from blood vessels, but OCT angiographic scans can not only identify abnormal vasculature, they can also be used to generate traditional OCT images, which can reveal fluid accumulation through structural changes in cross-sectional scans and thickness maps. Right now, fluorescein angiographic imaging is a useful adjunctive imaging modality, but in the future all that will be needed is OCT angiography of the macula and widefield OCT imaging to provide a beautiful visualisation of the macula or posterior pole.
“We want faster. Because the faster you go, the more information you can collect about microvasculature changes.”
“What I see in the future is widefield OCT imaging and then ultra-widefield imaging for those very few cases where you want to get way out into the periphery. And between those two modalities you are going to have virtually every ocular disease process covered - whether you are looking at the retina or the optic nerve. The debate then centres on whether the chosen light source is spectral domain or swept-source technology. Currently the entry-level technology is spectral domain. It has significant limitations because of its scanning speed and wavelength penetration. What is so wonderful about swept-source OCT is you can see all the way to the back of the eye. Over the next few years, widefield swept-source technology, OCT angiography, and en face OCT imaging, all done with a single instrument, will image the posterior pole and capture the imagination of retina specialists.”
Figures 6 and 7: Retinal vein occlusion (ultra-widefield images courtesy of Optos).

Figures 8 and 9: Case examples from clinical sites: choroidal neovascularisation associated with AMD visualised using fluorescein angiography and optical coherence tomography angiography (images courtesy of Optovue, Inc, CA, USA).
“We have learned over the years that there is an enormous amount of information available if we look into the back of the eye using the traditional en face approach. We appreciate now that blood flow in the choroidal layers under the retinal pigment epithelium probably plays a crucial role in AMD. To fully understand diseases of the eye, you need to look at the microvasculature and the cross-sectional anatomy of the retina and choroid, a complex vasculature which provides all the nourishment to the outer retina. Swept-source OCT can scan at up to 400,000 A-scans per second, and every A scan is currency - the more the better and the more A-scans you have, the more imaging flexibility you have. We want faster. Because the faster you go, the more information you can collect about microvasculature changes.
“En face OCT allows users to look at the different layers and see how these are changing, providing powerful representation of different disease processes. Admittedly it is unclear how these newer-generation OCT technologies will influence the management of wet AMD until we get to test these new instruments in the clinic. Using conventional OCT for wet AMD, we don’t change our treatment regimen until there is leakage. But, if we can detect evidence of anatomic changes in the microvasculature before leakage, then we might preemptively treat prior to possible recurrent leakage. The studies need to get done.
“This technological leap also has the potential to help clinician scientists better understand underlying disease mechanisms in diseases such as dry AMD, a condition for which we do not have a treatment capable of significantly slowing the relentless progression. As we begin to better understand the microvasculature changes that occur in these diseases, then we’ll be able to identify the disease at an earlier stage and hopefully intervene even earlier with drugs currently in development.
“If I could only have just one instrument, I’d want a widefield swept-source OCT instrument capable of en face imaging with segmentation algorithms and OCT angiography. With just a three to four second scan through an undilated pupil I’d get all the information I need. All the other imaging modalities are unnecessary and incredibly tortuous for the patient. The future is OCT multidimensional imaging.”
Philip J Rosenfeld is Professor of Ophthalmology at the Bascom Palmer Eye Institute, Miami, FL, USA.
References
1. Puliafito CA. OCT angiography: the next era of OCT technology emerges. Ophthalmic Surg Lasers Imaging Retina 2014;45(5):360.
2. Schwartz DM, Fingler J, Kim DY, et al. Phase-variance optical coherence tomography: a technique for noninvasive angiography. Ophthalmology 2014;121(1):180-7.
3. Spaide RF, Klancnik JM Jr, Cooney MJ. Retinal vascular layers imaged by fluorescein angiography and optical coherence tomography angiography. JAMA Ophthalmol 2015;133(1):45-50.
4. Francis JH, Pang CE, Abramson DH, et al. Swept-source optical coherence tomography features of choroidal nevi. Am J Ophthalmol 2015;159(1):169-76.
5. Waldstein SM, Faatz H, Szimacsek M, et al. Comparison of penetration depth in choroidal imaging using swept source vs spectral domain optical coherence tomography. Eye (Lond) 2015 [Epub ahead of print].
6. Adhi M, Liu JJ, Qavi AH, et al. Choroidal analysis in healthy eyes using swept-source optical coherence tomography compared to spectral domain optical coherence tomography. Am J Ophthalmol 2014;157(6):1272-81.
7. Klufas MA, Yannuzzi NA, Pang CE, et al. Feasibility and clinical utility of ultra-widefield indocyanine green angiography. Retina 2014 [Epub ahead of print].
8. Patel M, Kiss S. Ultra-wide-field fluorescein angiography in retinal disease. Curr Opin Ophthalmol 2014;25(3):213-20.
9. Keane PA, Sadda SR. Retinal imaging in the twenty-first century: state of the art and future directions. Ophthalmology 2014;121(12):2489-500.
10. Grulkowski I, Liu JJ, Potsaid B, et al. Retinal, anterior segment and full eye imaging using ultrahigh speed swept source OCT with vertical-cavity surface emitting lasers. Biomed Opt Express 2012;3(11):2733-51.
TAKE HOME MESSAGE
-
Optical coherence angiography can produce rapid 3D maps of the retinal and choroidal vasculature, together with segmentation ability, identifying superficial and deep retinal capillaries
-
Better resolution and faster speed OCT angiography may provide a better understanding of vitreoretinal disease and response to therapy with superior qualitative and quantitative data
-
Swept-source OCT is an important part of the future of ophthalmic imaging, featuring deeper range of imaging, vitreous imaging and faster scanning speed
-
Other retinal imaging developments predicted to impact clinical and surgical ophthalmology include whole-eye OCT, handheld OCT devices and integrated intraoperative OCT instruments
-
Widefield and ultra-widefield imaging is fast evolving as a recognised standard of care for imaging the retina
COMMENTS ARE WELCOME